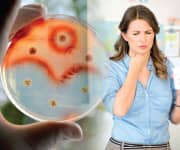
Novel Probiotic Fights Strep

Life Extension Magazine®
Strep throat (known to physicians as streptococcal pharyngitis) is caused by a group of bacteria known as type A streptococcus. Responsible for up to about 15% of sore throat infections in adults and up to about 30% in children, strep throat is characterized commonly by fever, painful swallowing, and tender, enlarged lymph nodes in the neck.1
Although most of the time in adults the cause of a sore throat is viral in origin, and therefore antibiotics are of no use, in the case of confirmed strep throat, antibiotic treatment is important to prevent dangerous consequences, like rheumatic heart disease or retropharyngeal abscess .1,2
At a time when antibiotics were not available, many people suffered as a consequence of inadequate treatment of strep throat.
While antibiotic treatment of confirmed strep throat is important to prevent the potential for rheumatic heart disease and other complications, an opportunity exists to reduce the risk of strep infection in the first place.
The intriguing news is that scientists have identified a novel probiotic, known as S. salivarius K12, and studies suggest that this targeted probiotic lozenge may reduce the risk of strep throat. In addition, this probiotic also appears capable of reducing the incidence of non-strep, viral sore throats as well.
Sore Throats: Significant Adult Problems
There are few “minor” illnesses as irritating as a sore throat.
Unfortunately, there’s no good way to discern whether an infectious sore throat is caused by a bacteria or virus based solely on clinical symptoms in isolation. Sore throat caused by a potentially dangerous organism like Streptococcus pyogenes (strep throat), however, tends to be more severe, and accompanied by (high) fever, but not always.1
In the majority of cases a sore throat is caused by a virus.3
Antibiotics are of no use in viral infections. Unfortunately, over prescribing antibiotic treatment in the face of any sore throat continues, though to a lesser degree over the past several years since most physicians and patients are aware of the unnecessary problems antibiotics cause.4
Bacterial infection with pathogenic organisms like Streptococcus pyogenes is the only real indication for antibiotic use. This particular organism produces a painful sore throat (“strep throat”) that can last three to five days, and can also cause long-term complications such as rheumatic heart disease, retropharyngeal abscess, and post-streptococcal glomerulonephritis (kidney disease).1,2 These conditions are rare today in comparison with the era prior to antibiotics, but concerns remain high, with overprescribing of antibiotics a consequence.3
Overprescribed antibiotics are a known public health problem, particularly in adults with upper respiratory tract infections such as sore throat.5,6 These practices contribute to the emergence of “superbugs” that are difficult to treat and have the potential to produce dangerous infections.7-9 And indiscriminate antibiotic use also creates problems by producing an imbalance of the gastrointestinal (GI) microbiome, the population of healthy organisms that lives in our GI tract and has tremendous impact on overall health.10
And because it is impossible to tell at home if a sore throat is caused by strep, many people with sore throats visit their physicians, and research suggests that potentially up to 75% of adult patients receive antibiotic treatment for what ultimately turns out to be nonbacterial in origin.3
What this all adds up to is that we need a way to reduce the risk of any kind of sore throat in adults. That will help reduce the incidence of genuine, antibiotic-requiring cases of sore throat caused by bacteria, such as strep throat, and also minimize the number of physician visits for sore throat that might result in inappropriate antibiotic prescribing.
And that’s where the beneficial, probiotic S. salivarius K12 comes in, as we’ll now see.
Novel Probiotic Fights Strep
There is a new method for fighting and reducing the risk of strep throat infection.
The beneficial S. salivarius probiotic strain was discovered in the 1980s in cultures from individuals who seemed resistant to developing sore throats.12,13 That search yielded a specific strain of S. salivarius called K12, which is found in only about 2% of individuals who show a natural resistance to strep throat.14 With sufficient numbers of this bacterial strain, it can keep disease-causing organisms such as Streptococcus pyogenes under control.12,15
One of its key properties is that S. salivarius K12 produces compounds called lantibiotics.16 These lantibiotics strongly inhibit many strains of disease-producing Streptococcus pyogenes responsible for causing strep throat in humans.15 As a result, disease-causing organisms may be prevented.
Salivaricin A2, a type A lantibiotic produced by S. salivarius K12, works like a drill that forms molecular pores in the membranes of target organisms, permitting them to leak out their contents into surrounding fluid and then break apart and die.15-19
But that’s not where the benefits of S. salivarius K12 end. While the mechanisms are still being investigated, there is now evidence that S. salivarius K12 colonization of the throat reduces secretion of the inflammatory signaling molecule (cytokine) IL-8, and increases concentrations of the antiviral compound interferon-gamma.18 These properties may account for observation that children treated with S. salivarius K12 had a significant reduction in both viral and bacterial sore throats.18
What You Need To Know
 |
Stop Sore Throats Without Dangerous Drugs
- Sore throats are a major problem in adults as well as children.
- Even strep throat, considered a “childhood illness,” is known to occur in adults, though less frequently.
- While most sore throats are caused by viruses and are merely uncomfortable, strep throat can produce dangerous complications like rheumatic heart disease, retropharyngeal abscess, and kidney disorders.
- Instead of waiting for a sore throat to develop and taking your chances with or without antibiotics, you can proactively work to prevent sore throats of all kinds, including potentially dangerous strep.
- Probiotic bacteria S. salivarius K12 produces potent, locally acting lantibiotics, compounds that target the organisms that cause strep throat.
- Clinical studies demonstrate a significant reduction in strep throat infections in people supplementing with this probiotic in the form of a daily oral lozenge.
- Remarkably, studies also show that S. salivarius K12 contributes to a reduction in viral sore throats as well. This property is attributed to the probiotic’s impact upon certain signaling molecules (cytokines), including interferon-gamma.
- Regular use of probiotic S. salivarius K12 may help you dodge the upcoming winter sore throat season.
Clinical Evidence
A growing body of evidence demonstrates the effectiveness of the probiotic S. salivarius K12 in helping to reduce the risk of sore throats of all kinds.
A randomized, controlled clinical trial was performed among a group of adults to determine the effects of S. salivarius K12 oral therapy on the number and severity of episodes of proven strep throat. Subjects were people with a history of recurrent strep throat or tonsillitis (four or more proven episodes in the preceding year).21
Subjects were free of symptoms at enrollment in the study. They were started on either a daily lozenge containing S. salivarius K12 organisms, or given no treatment. Treatment was given daily for 90 days. Subjects were then followed for an additional six months with no further treatment.
Treated adults who completed the 90-day course of supplementation had a significant 84% reduction in their incidence of strep throat or tonsillitis compared with the previous year.
Even during the six-month, no-treatment follow-up period, patients who underwent the original 90-day supplement experienced a significant 62% reduction in episodes of strep throat or tonsillitis, compared with the untreated group.
This study therefore demonstrated that preventive treatment with S. salivarius K12 was effective at significantly reducing the rates of recurrent strep disease. That’s a first.
In a similar study targeting school-age children with recurrent strep infections, treatment with S. salivarius K12 was given for 90 days.22 Again, the subjects were followed for six additional months after the supplementation period.
At the 90-day mark, supplemented children demonstrated a 92% reduction in strep throat, compared with the previous year. Again, there was a significant reduction (this time 66%) in the rate of strep throat infections in the six months following the end of the supplementation period.22
In an important additional finding, the rate of acute ear infections in this group of children was also significantly reduced by about 40% in the supplemented group, compared with the previous year.21 This suggests that not only Streptococcus pyogenes, but also potentially other disease-causing organisms, are susceptible to this preventive treatment.
In a third study, children with recurrent strep throat were supplemented for 90 days with S. salivarius K12 (1 billion organisms per lozenge), or given no therapy.18
Supplemented children showed a significant 97% reduction in strep throats, from a baseline of 3.1 infections per child in the year prior to the study to just 0.1 infection per child in the year of the study, with no significant change seen in the unsupplemented group.18
Remarkably, the supplemented patients also had a significant (and unprecedented) 80% decrease in the incidence of oral and throat viral infections. The researchers speculated that this reduction might be related to a known ability of S. salivarius K12 to reduce inflammatory IL-8 and increase anti-viral interferon-gamma.18,23
Summary
Sore throats affect most everyone, causing loss of work, sleep, and quality of life.
Strep throats caused by pathogenic type A streptococcus bacteria strains can strike both children and adults.
The novel probiotic supplement S. salivarius K12 now available in a once-daily lozenge, produces potent, natural, locally acting lantibiotics, a class of compounds that may reduce the risk of throat infection.
S. salivarius K12 has now been clinically documented to reduce the incidence of strep throat infections in both adults and children. In an intriguing finding, people who supplemented with this probiotic also appeared to be protected against viral throat infections as well.
Viral infections are the leading cause of sore throats, and although viruses are unfazed by antibiotics, antibiotic treatment is often prescribed, contributing to their inappropriate use.
If you have any questions on the scientific content of this article, please call a Life Extension® Health Advisor at 1-866-864-3027.
References
- Shulman ST, Bisno AL, Clegg HW, et al. Clinical practice guideline for the diagnosis and management of group A streptococcal pharyngitis: 2012 update by the Infectious Diseases Society of America. Clinical infectious diseases: an official publication of the Infectious Diseases Society of America. Clin Infect Dis. 2012 Nov 15;55(10):e86-102.
- Karmarkar MG, Hule GP, Cameron A, et al. Antibodies to group A streptococcal virulence factors, SIC and DRS, increase predilection to GAS pyoderma. BMC Infect Dis. 2015;15:113.
- Perone N, Humair JP. Diagnosis and management of pharyngitis. Rev Med Suisse. 2007 Jan 31;3(96):286-90.
- West JV. Acute upper airway infections. Br Med Bull. 2002;61:215-30.
- Dekker AR, Verheij TJ, van der Velden AW. Inappropriate antibiotic prescription for respiratory tract indications: most prominent in adult patients. Fam Pract. 2015 Aug;32(4):401-7.
- Gulliford MC, Dregan A, Moore MV, et al. Continued high rates of antibiotic prescribing to adults with respiratory tract infection: survey of 568 UK general practices. BMJ Open. 2014;4(10):e006245.
- Special Report. The rise of superbugs. Consum Rep. 2015 Aug;80(8):20-6.
- Blondeau J. Gram-negative superbugs: inappropriate antimicrobial therapy and mortality. Expert Rev Clin Pharmacol. 2013 Jul;6(4):347-9.
- Dawson MP, Smith AJ. Superbugs and the dentist: an update. Dent Update. 2006 May;33(4):198-200, 02-4, 07-8.
- Modi SR, Collins JJ, Relman DA. Antibiotics and the gut microbiota. J Clin Invest. 2014 Oct;124(10):4212-8.
- Available at: http://www.niaid.nih.gov/topics/streptococcal/pages/default.aspx. Accessed September 21, 2015.
- Fantinato V, Jorge AOC, Shimizu MT. Production of bacteriocin-like inhibitory substances (BLIS) by Streptococcus salivarius strains isolated from the tongue and throat of children with and without sore throat. Revista de Microbiologia. 1999;22(30):332-34.
- Dempster RP, Tagg JR. The production of bacteriocin-like substances by the oral bacterium Streptococcus salivarius. Arch Oral Biol. 1982;27(2):151-7.
- Burton J, Chilcott C, Wescombe P, et al. Extended safety for the oral cavity probiotic streptococcus salivarius K12. Probiotics & Antimicro. Prot. 2010;2:135-44.
- Wescombe PA, Upton M, Dierksen KP, et al. Production of the lantibiotic salivaricin A and its variants by oral streptococci and use of a specific induction assay to detect their presence in human saliva. Appl Environ Microbiol. 2006 Feb;72(2):1459-66.
- Hyink O, Wescombe PA, Upton M, et al. Salivaricin A2 and the novel lantibiotic salivaricin B are encoded at adjacent loci on a 190-kilobase transmissible megaplasmid in the oral probiotic strain Streptococcus salivarius K12. Appl Environ Microbiol. 2007 Feb;73(4):1107-13.
- Walls T, Power D, Tagg J. Bacteriocin-like inhibitory substance (BLIS) production by the normal flora of the nasopharynx: potential to protect against otitis media? J Med Microbiol. 2003 Sep;52(Pt 9):829-33.
- Di Pierro F, Colombo M, Zanvit A, et al. Use of Streptococcus salivarius K12 in the prevention of streptococcal and viral pharyngotonsillitis in children. Drug Healthc Patient Saf. 2014;6:15-20.
- Gillor O, Etzion A, Riley MA. The dual role of bacteriocins as anti- and probiotics. Appl Microbiol Biotechnol. 2008;81(4):591-606.
- Draper LA, Cotter PD, Hill C, et al. Lantibiotic resistance. Microbiol Mol Biol Rev. 2015 Jun;79(2):171-91.
- Di Pierro F, Adami T, Rapacioli G, et al. Clinical evaluation of the oral probiotic Streptococcus salivarius K12 in the prevention of recurrent pharyngitis and/or tonsillitis caused by Streptococcus pyogenes in adults. Expert Opin Biol Ther. 2013 Mar;13(3):339-43.
- Di Pierro F, Donato G, Fomia F, et al. Preliminary pediatric clinical evaluation of the oral probiotic Streptococcus salivarius K12 in preventing recurrent pharyngitis and/or tonsillitis caused by Streptococcus pyogenes and recurrent acute otitis media. Int J Gen Med. 2012;5:991-7.
- Wescombe PA, Hale JD, Heng NC, et al. Developing oral probiotics from Streptococcus salivarius. Future Microbiol. 2012 Dec;7(12):1355-71.

